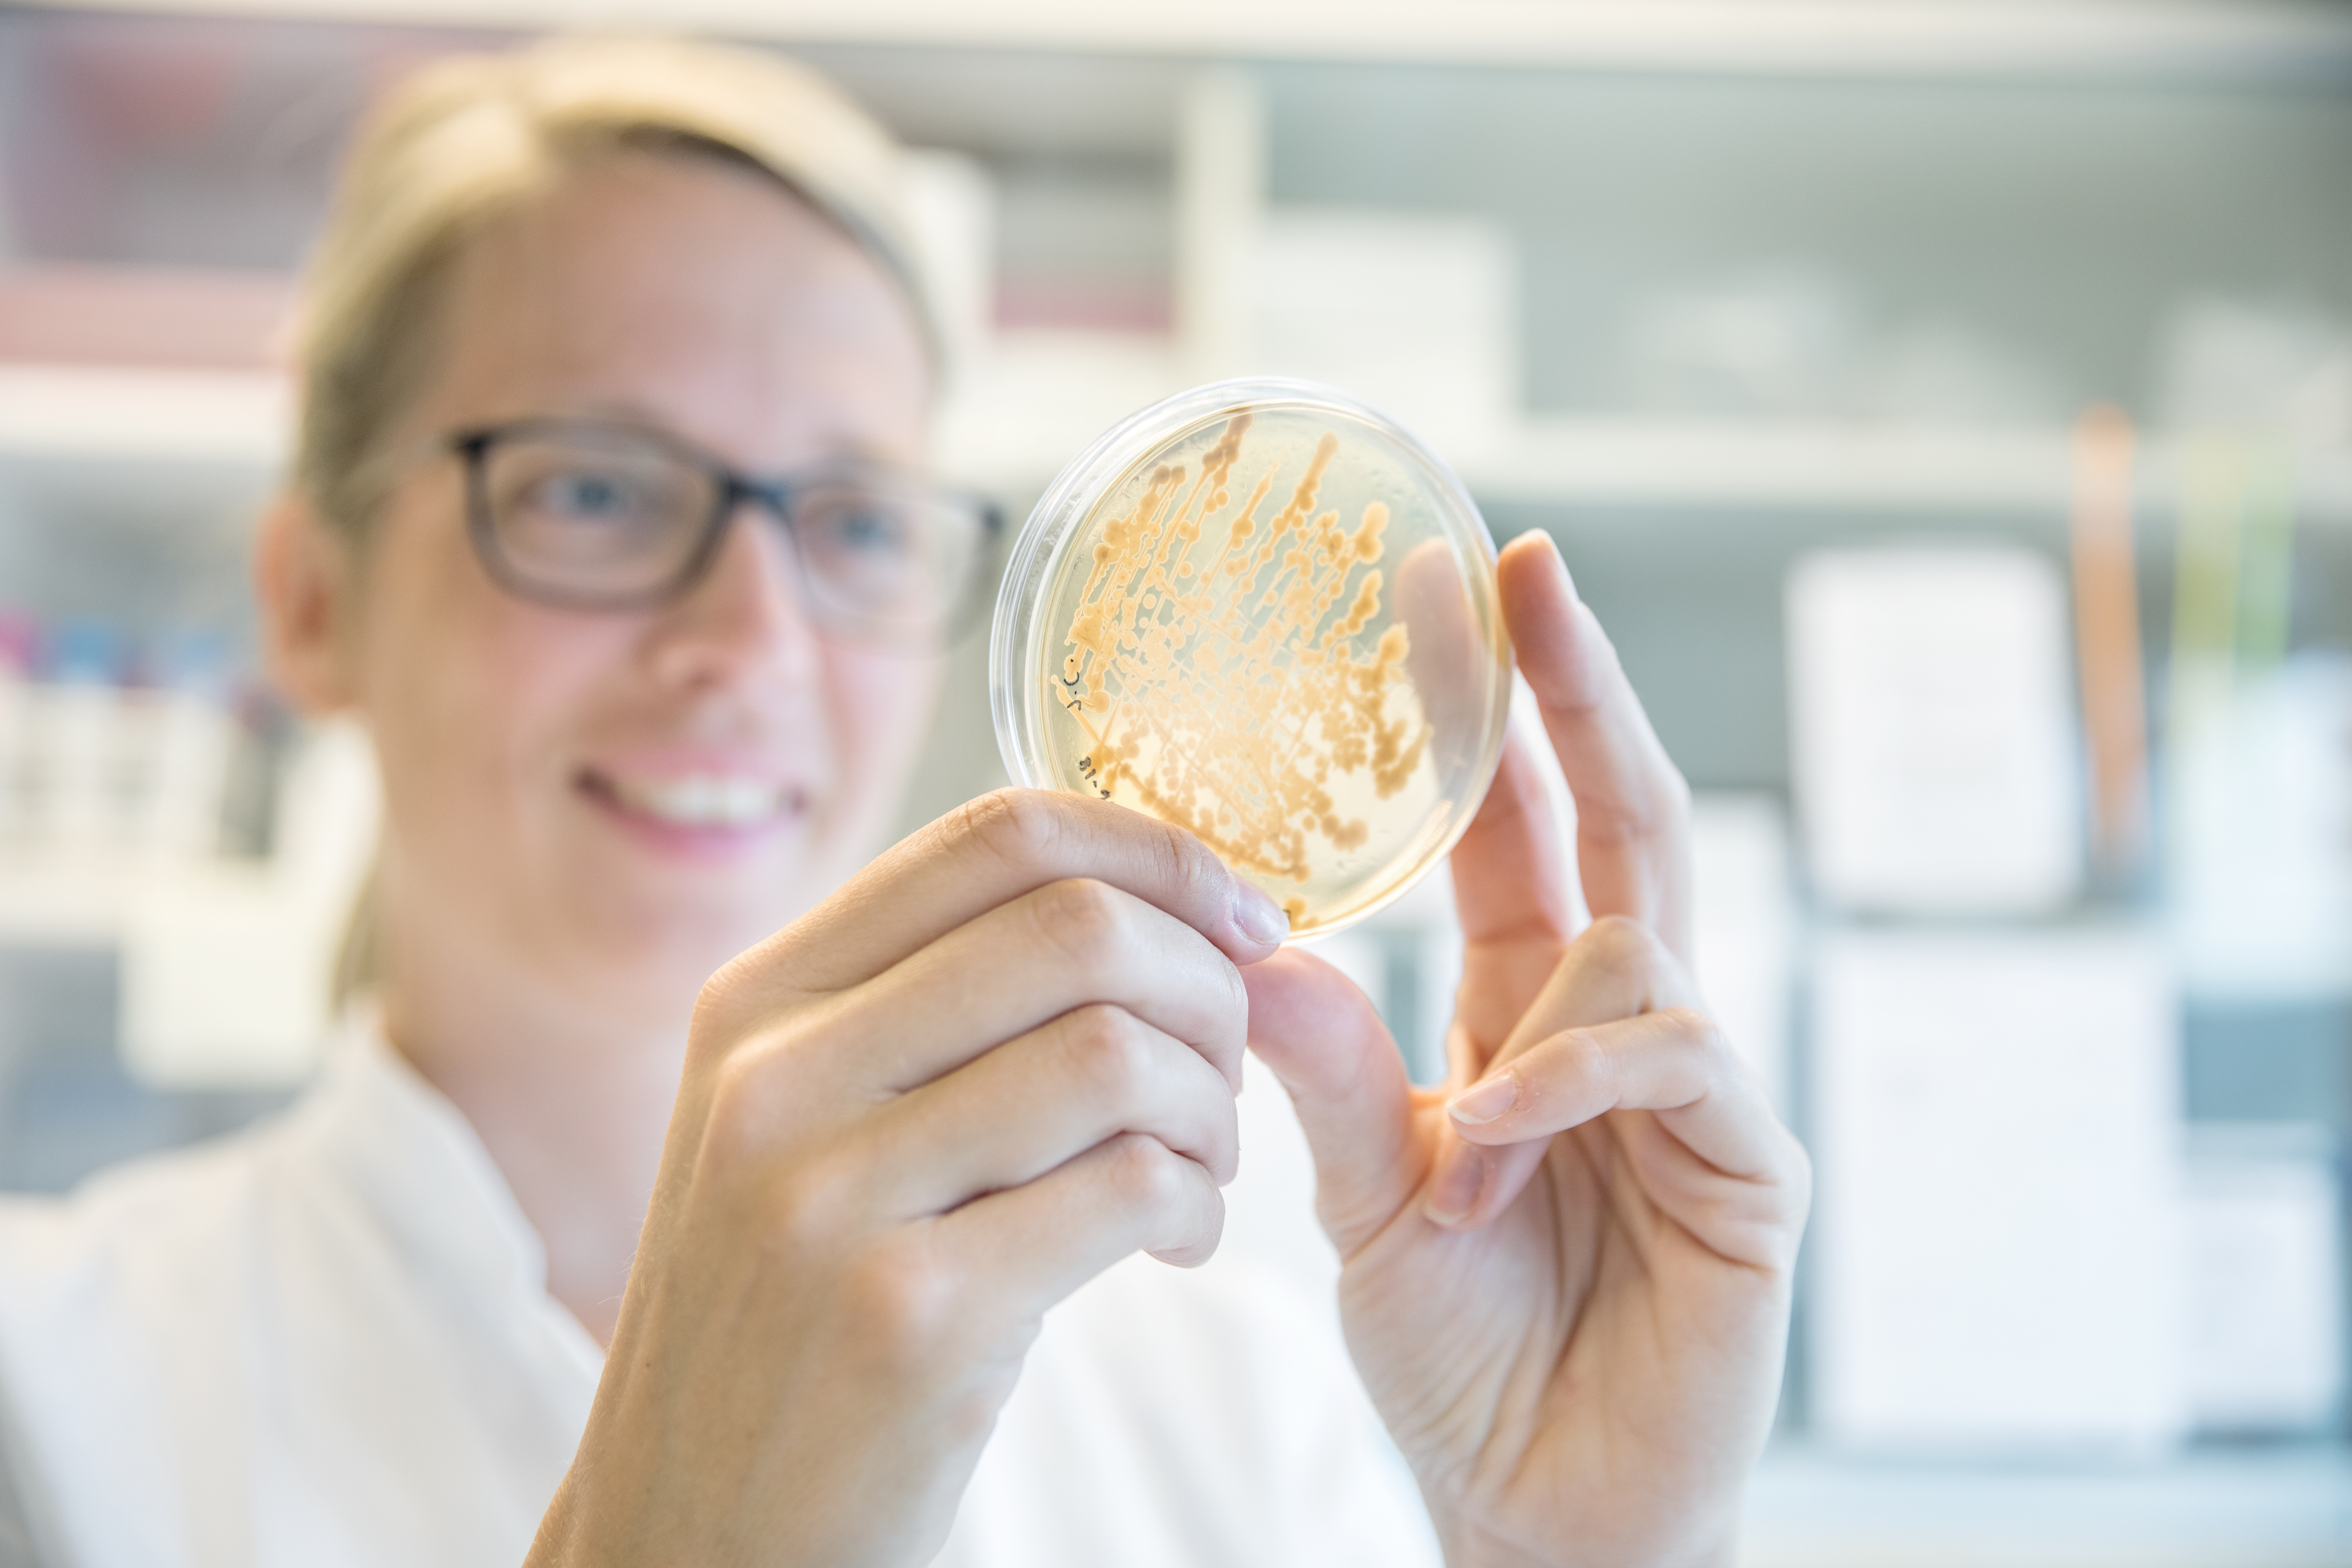
Norce miljø 09, ,

Ferskvannsøkologi og forvaltning av villaksen
Vi samspiller med miljømyndigheter og vannkraftselskaper om hvordan livskraftige bestander med villfisk kan sikres, og iverksetter tiltak som miljøbasert flomsikring. Vi driver vi forskning, overvåking, tiltak og utredninger innen ferskvannsøkologi og har over 50 års erfaring, inkludert spesiell kompetanse på laksefisk (laks, sjøaure, innlandsaure) og bunndyr, og på hvilke miljøbetingelser som skal være til stede for at disse artene skal ha livskraftige bestander.
Lang erfaring med miljøovervåking
Vi foretar miljøovervåkning og kartlegger miljøendringer i elver, fjorder og havområder. Gjennom vår kartlegging av miljøendringer over tid har 30 år lange dataserier som også brukes for å modellere havstrømmer for optimal plassering av oppdrettsanlegg, anbefale tidspunkter for avlusing i anleggene, og bistå oljesektoren.
I andre prosjekt forsker vi på nye fôrkilder til oppdrettslaks, samtidig som vi utvikler industrielle enzymer som den marine produktindustrien trenger for å øke verdien av restråstoff.
Vi skaffer kunnskap om hvilke antibiotikaresistens gener som finnes i miljø og om hvordan dette påvirker menneskers og dyrs helse (en-helse perspektiv).
Vi har laboratorier i Bergen, Tromsø og Stavanger med effektive analyseverktøy for å løse samfunnets og næringens utfordringer med blant annet marin plastforsøpling.